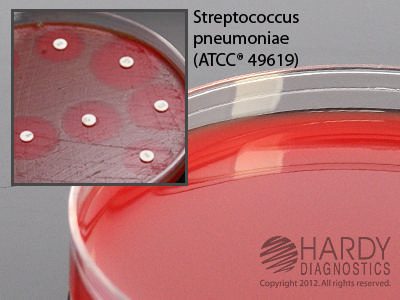

Bioreagents
HardyDisk AST , Hardy Diagnostics – Z9015, Sulfamethoxazole/Trimethoprim, SXT
$47.38SULFAMETHOXAZOLE/TRIMETHOPRIM HARDYDISKS
HardyDisk AST , Hardy Diagnostics – Z9125, Tetracycline, Te-30
$48.52TETRACYCLINE TE-30 HARDYDISKS AST 30 UG
Healthlink Transport Swab with Amies Liquid, Hardy Diagnostics – 4140BX, Transport Swab with Amies Liquid
$54.72SWAB TRANSPORT W/AMIES LIQ RAYON TIP
CRITERION Dehydrated Culture Media, Barney Miller Broth with Indicator, Hardy Diagnostics – C8992, 2 kg, Barney Miller Broth with Indicator
$588.49BROTH BARNEY MILLER WITH INDICATOR 2 KG
BCYE Agar (Buffered Charcoal Yeast Extract), Hardy Diagnostics – G07, 15 x 100 mm, BCYE Agar, HDx
$58.37BCYE AGAR PLATE 15X100MM F/LEGIONELLA SP
Mycobiotic Agar Slant, Hardy Diagnostics – L45, Mycobiotic Agar Slant
$59.31SLANT MYCOBIOTIC AGAR 20X125MM TUBE 10ML
LB (Lennox L) Agar with Ampicillin, Hardy Diagnostics – G79, LB Agar, Lennox w/Amp
$69.78LB AGAR WITH AMPICILLIN 15 X 100MM PLATE
BCYE Selective Agar with CAV Antibiotics, Hardy Diagnostics – G08, BCYE Selective Agar w/CAV
$70.37AGAR BCYE SLCTV W/CAV ATB 15X100MM PLATE
Trichophyton Agar, Hardy Diagnostics – C51, 20 x 125 mm, Trichophyton #1
$140.73TRICHOPHYTON AGAR NUMBER 1 10.5 ML SLANT
Neutralizing Buffer, Hardy Diagnostics – K105, Pack of 20, Neutralizing Buffer
$63.03BUFFER NEUTRALIZING 16 X 125MM TUBE 10ML
Mueller Hinton Agar with Blood, Hardy Diagnostics – H21, Mueller Hinton Agar w/Bld, HDx
$40.69AGAR MUELLER HINTON W/BLD 15X150MM PLT L